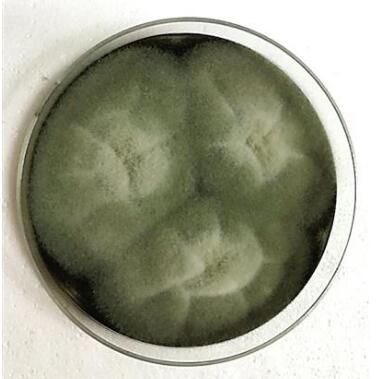

以上是不同患者培養(yǎng)出的形態(tài)各異的真菌
吳護(hù)平教授給患者檢查眼睛
吳護(hù)平已經(jīng)在廈門(mén)眼科中心眼表及角膜病科室待了二十多年了。當(dāng)年是以該院研究生的身份進(jìn)去的,不知不覺(jué)間,他已經(jīng)成為了廈大醫(yī)學(xué)院教授,并陸陸續(xù)續(xù)培養(yǎng)了好幾名博士后。相比于科室及個(gè)人獲得的榮譽(yù),讓他記憶尤為深刻的是一個(gè)個(gè)“不可思議”的患者故事。
外地翼狀胬肉患者,常常一個(gè)村一個(gè)小區(qū)的來(lái)
57歲的楊阿姐,是江西瑞金人,左眼患上翼狀胬肉已經(jīng)十多年了,常常眼睛干澀,有異物感,胬肉牽扯著眼球很不舒服。雖然想手術(shù),但身邊很多人手術(shù)后又復(fù)發(fā)了,聽(tīng)得多了,楊阿姐也有些灰心了。即使當(dāng)?shù)氐囊頎铈廊馐中g(shù)是免費(fèi)的,楊阿姐也不想做,這一拖就是好多年。
從鄰居謝大姐那兒打聽(tīng)到廈門(mén)眼科中心的胬肉手術(shù)一直都無(wú)人復(fù)發(fā),她才打定了主意要異地手術(shù)。“免不免費(fèi)對(duì)我來(lái)說(shuō)不重要,狀態(tài)好才是最重要的。”楊阿姐說(shuō)。
“我國(guó)大部分醫(yī)院把胬肉手術(shù)當(dāng)做小手術(shù),由低年資醫(yī)生作為提升手術(shù)技術(shù)的進(jìn)階手術(shù),施用麻醉劑后只進(jìn)行簡(jiǎn)單切除,手術(shù)時(shí)間過(guò)長(zhǎng),誤切除肌肉或血管組織等原因,導(dǎo)致復(fù)發(fā)率高達(dá)50%-60%。而一旦復(fù)發(fā),隨后的治療比初次手術(shù)麻煩數(shù)倍。”而眼科中心團(tuán)隊(duì)都是由高年資醫(yī)師作為主刀醫(yī)師,其中我國(guó)眼科學(xué)會(huì)學(xué)組委員3人,博士、碩士生導(dǎo)師4人,技術(shù)嫻熟。還引進(jìn)高端顯微鏡和高射頻技術(shù)等技術(shù)。手術(shù)時(shí)間短只要一二十分鐘就可完成,能有效避免翼狀胬肉患者再次成為二手患者。
術(shù)后的舒適和美觀(guān),讓楊阿姐十分欣喜。小區(qū)里多位老鄰居在她的建議下結(jié)伴來(lái)廈手術(shù)。像楊阿姐這樣的,還有龍巖、三明等地的患者,他們通常都是村里的人介紹來(lái)的,好口碑一傳十、十傳百。連我國(guó)眼科界的工程院院士謝立信教授都感嘆道,“廈門(mén)眼科中心眼表團(tuán)隊(duì)做了一件‘不可思議’的事。”
臺(tái)灣沒(méi)有的技術(shù)廈門(mén)有,臺(tái)北95后小伙只身來(lái)廈
22歲的臺(tái)北小伙小李,角膜異于常人,向前突出。一年前,他的右眼視力開(kāi)始持續(xù)下降,一開(kāi)始戴眼鏡還有用,后來(lái),眼鏡就不管用了。他在臺(tái)北當(dāng)?shù)氐尼t(yī)院檢查,診斷為“右眼圓錐角膜”,醫(yī)生建議,如果想更有效地控制病情,就得進(jìn)行角膜交聯(lián)手術(shù),而臺(tái)灣的所有醫(yī)院都還沒(méi)有開(kāi)展此項(xiàng)技術(shù)。
小李在一個(gè)社群里,看到有患友分享了在廈門(mén)做角膜交聯(lián)手術(shù)的經(jīng)歷,這位患友三年了視力還保持良好。他進(jìn)一步了解到,廈門(mén)眼科中心早在十年前就開(kāi)展了角膜交聯(lián)手術(shù),是國(guó)內(nèi)先行開(kāi)展交聯(lián)手術(shù)的機(jī)構(gòu)之一。而且該院吳護(hù)平教授和林志榮博士所著的《角膜膠原交聯(lián)技術(shù)及臨床應(yīng)用》一書(shū),是臨床醫(yī)生開(kāi)展角膜交聯(lián)技術(shù)的必看書(shū)籍。小李決定來(lái)廈進(jìn)行手術(shù)。
術(shù)后,小李很開(kāi)心,打算等右眼恢復(fù)后,擇期進(jìn)行左眼的預(yù)防性交聯(lián)手術(shù)。他透露,選擇廈門(mén)眼科中心還有一個(gè)很機(jī)靈的原因,“我查到廈門(mén)眼科中心眼庫(kù),是中國(guó)十大眼庫(kù)之一,萬(wàn)一醫(yī)生檢查出,我做不了交聯(lián)手術(shù),需要角膜移植,我也可以更快地等到角膜。”
圓錐角膜一般是青少年患者居多,每年寒暑假,都是臺(tái)灣同胞來(lái)廈手術(shù)的高峰期,一是距離近,還有就是技術(shù)好口碑好。
為每一位真菌感染的患者,都進(jìn)行藥敏測(cè)驗(yàn)
說(shuō)起真菌感染,大家先想到的可能是腳氣。其實(shí)自然界存在大量的真菌,特別是在植物上,公園里的一根樹(shù)枝、一片落葉、田地里的甘蔗葉、稻草若不小心打到眼睛,都可能傷及角膜,引發(fā)真菌感染。
三明人老劉,在山上拔竹根的時(shí)候,不小心被竹枝打到左眼。疼痛難忍的老劉,眼睛縫了7-8針,也用了藥,但一直不見(jiàn)好,畏光流淚,幾乎看不見(jiàn)了。找到吳護(hù)平教授求治時(shí),距離受傷已經(jīng)20多天了。經(jīng)過(guò)對(duì)角膜上壞死組織的化驗(yàn),診斷為“左眼真菌性角膜潰瘍”。由于拖延時(shí)間長(zhǎng),僅用抗真菌藥物已經(jīng)無(wú)法控制病情,必須通過(guò)角膜移植手術(shù)來(lái)治療。吳護(hù)平教授為老劉實(shí)施了左眼穿透性角膜移植術(shù),老劉的感染控制住了,疼痛也消失了。
真菌感染致盲率高,容易反復(fù),治療起來(lái)相對(duì)困難。治療和用藥對(duì)于患者來(lái)說(shuō)至關(guān)重要。然而迄今發(fā)現(xiàn)70余種真菌可引起角膜感染。
所以近期廈門(mén)眼科中心檢驗(yàn)科,在廈門(mén)先行開(kāi)展了絲狀真菌藥物敏感測(cè)驗(yàn),作為臨床治療用藥參考。每一名來(lái)就診的真菌感染患者,只要能培養(yǎng)出絲狀真菌,都給他們做藥敏測(cè)驗(yàn)。通過(guò)真菌培養(yǎng)及藥敏測(cè)驗(yàn),解決三大問(wèn)題:1、究竟感染了哪種真菌?2、哪種藥物對(duì)患者更有效?3、多少劑量更為合適?使醫(yī)生在開(kāi)藥的時(shí)候,更加有據(jù)可依。